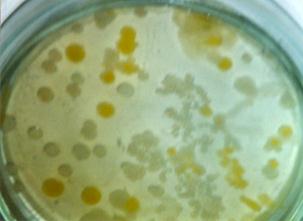
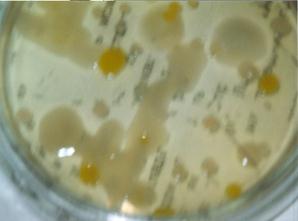

КАТЕГОРИИ:
Архитектура-(3434)Астрономия-(809)Биология-(7483)Биотехнологии-(1457)Военное дело-(14632)Высокие технологии-(1363)География-(913)Геология-(1438)Государство-(451)Демография-(1065)Дом-(47672)Журналистика и СМИ-(912)Изобретательство-(14524)Иностранные языки-(4268)Информатика-(17799)Искусство-(1338)История-(13644)Компьютеры-(11121)Косметика-(55)Кулинария-(373)Культура-(8427)Лингвистика-(374)Литература-(1642)Маркетинг-(23702)Математика-(16968)Машиностроение-(1700)Медицина-(12668)Менеджмент-(24684)Механика-(15423)Науковедение-(506)Образование-(11852)Охрана труда-(3308)Педагогика-(5571)Полиграфия-(1312)Политика-(7869)Право-(5454)Приборостроение-(1369)Программирование-(2801)Производство-(97182)Промышленность-(8706)Психология-(18388)Религия-(3217)Связь-(10668)Сельское хозяйство-(299)Социология-(6455)Спорт-(42831)Строительство-(4793)Торговля-(5050)Транспорт-(2929)Туризм-(1568)Физика-(3942)Философия-(17015)Финансы-(26596)Химия-(22929)Экология-(12095)Экономика-(9961)Электроника-(8441)Электротехника-(4623)Энергетика-(12629)Юриспруденция-(1492)Ядерная техника-(1748)
Перспективи розвитку вапняно-вуглекислого очищення
|
|
|
|
Безперечно, основним показником, що визначає ефективність такого очищення, є висока технологічна якість цукрових буряків, а значить і чистота дифузійного соку. Так, наприклад, за кордоном (Польща, Німеччина)остання складає 90,5...91,2 % проти 85,0...87,0 в Україні. Звідси і відповідна витрата вапна (1,5..1,6 % СаО проти 2,5..2,8 % СаО у нас), вихід та якість цукру, його собівартість. Тому першим етапом процесу перероблення буряків повинна бути висока ступінь їх відмивання, особливо від піску, глини і гички, які спричиняють до різкого підвищення розчинних ВМС та кремнієвих сполук, що погіршує фільтрацію.
У зв’язку із все ширшим застосуванням фільтрпресів, які дозволяють відділяти фільтраційний осад навіть при Fк ≤ 7,5, необхідно проводити дослідження по попередньому обробленні дифузійного соку (попередньому вапнуванні) з метою скорочення тривалості процесу ПД та різкого скорочення повертань, а значить і витрат вапна. Потребує подальших досліджень і вдосконалення процесу основної дефекації з метою одержання більш термостійких соків та більш повного розкладу амідів і видалення аміаку до випарної станції. З цього приводу необхідно також продовжити дослідження по підвищенню активності вапняного молока та підвищення його густини шляхом покращення реологічних властивостей.
застосування імпульсних електроплазмолізаторів в бурякопереробному відділенні. Удосконалення технології цукрового виробництва та підвищення ефективності перероблення бурякової сировини неможливе без підвищення якості дифузійного соку. Одним із ефективних напрямків є розробка та застосування електротехнологій.
Встановлено [4], що серед різних факторів, які суттєво впливають на стійкість клітинних мембран, особливе місце займає імпульсне електричне поле високої напруги (Е = 10000 В/см, довжина імпульсів t = 10-6 с) та його взаємодія з клітинними структурами бурякової стружки, компонентами дифузійного соку та інших продуктів цукрового виробництва. Доведено, що ефективність імпульсного електроплазмолізу тканини цукрового буряка залежить від напруженості електричного поля, тривалості імпульсів та міжімпульсних пауз. Лабораторні та промислові дослідження показали, що оптимальним є проведення комбінованої термічно-електричної обробки з попереднім нагріванням сокостружкової суміші до температури 60…65 о С, що забезпечує мінімізацію енерговитрат на процес електроплазмолізу.
За останні роки запропоновано принципово нові конструкції електроплазмолізаторів з плоско паралельним розміщенням електродів (дво- і трикамерні) та запропонований універсальний блок живлення (рис….):
Рис. 1 Купчик
На Карлівському та Первухінському ц/з змонтовані та працюють декілька сезонів такі установки, встановлені на трубопроводі сокостружкової суміші після ошпарювала перед колоною дифузійного апарату. Промислові випробування показали наступні результати, наведені в таблиці.
| № | Показники | Спосіб екстрагування | |
| Типовий | З електрооб-робленням | ||
| Ступінь плазмолізу | 40…45 | 84…85 | |
| Температура сокостружкової суміші, о С | 70..75 | 65… | |
| Відкачка дифузійного соку, % | 125…130 | 115…120 | |
| Ефект очистки на дифузії, % | 8…12 | 20…25 | |
| Продуктивність дифузійної установки, т/год | |||
| Використання формаліну | так | ні | |
| Втрати цукрози в жомі, % від к.б. | 0,3…0,4 | 0,17…0,26 | |
| Невраховані втрати, % від к.б. | 0,15..0,31 | 0,05…0,18 | |
| Витрати електроенергії, кВт год/т буряків | - | 0,36…0,67 |
3,5. Застосування е лектргідровлічного ефекту. Дослідження професора Купчика М.П.[3] по впливу електричного поля на процес екстракції цукрози з подрібнених буряків одночасно виявили його знезаражуючу дію на мікрофлору дифузійного соку. А саме, з підвищенням напруженості електричного поля від 0В/м до 1000 В/м в дифузійному соку зменшується кількість деяких мікроорганізмів по відношенню до необробленого соку. Виявлено, що при збільшенні напруженості кількість термофілів знизилась на 80%, мезофілів – на 80%, слизоутворюючих мезофілів – на 90%, дріжджових грибів - на 30%, пліснявих грибів зменшилась на 50% в порівнянні з дифузійним соком, добутим традиційним методом.
Пригнічуюча дія електричного поля на життєдіяльність мікроорганізмів спостерігається вже за напруги 250 В/м, що пояснюється більш високою локаль-ною напругою електричного поля в зазорах між частинками бурякової стружки.
В останні роки в технології харчових виробництв широкого застосування набуло використання електрогідравлічного ефекту, який є наслідком електроіскрового розряду в рідині [5].
Електрогідравлічний ефект – це складний комплекс фізичних і хімічних явищ, які виникають під час високовольтних електроімпульсних розрядів в рідині: високий тиск, потужні ударні хвилі, кавітаційні процеси, утворення парогазової бульбашки та її пульсація, світлове свічення каналу розряду, іонізація та розклад молекул речовини в плазмі каналу і біля нього, інтенсивне ультрафіолетове та ультразвукове випромінювання, імпульсні магнітні та електричні поля. Ці процеси виникають миттєво і призводять до різноманітних фізико-хімічних змін самої рідини і тих об’єктів, які знаходяться в ній [5].
Всі ці дії, а саме ударна хвиля, ультрафіолетове випромінювання, поява продуктів термолізу та електролізу рідини, в різному ступені здійснюють на присутні в рідині мікроорганізми знезаражуючу (бактерицидну) дію, процес протікання якої можна розглядати наступним чином. В момент розряду в рідині виникають отруйні для мікроорганізмів вторинні продукти розщеплення її молекул у вигляді вільних радикалів та атомарного водню. Під дією утворених продуктів проходить розкладання амінокислот і білків, деполяризація нуклеїнових кислот, розщеплення інших біологічно-активних речовин.
В момент електроімпульсного розряду в рідині утворюється безрідинний канал. Протягом декількох мікросекунд із каналу витісняється вся рідина. Швидке виділення енергії в каналі визначає вибуховий характер процесу, який обумовлює підвищення тиску до надзвичайних величин. Саме накопичення вторинних продуктів розщеплення молекул рідини та надзвичайний тиск призводять до деформації та руйнування клітин мікроорганізмів, що і здійснює бактерицидну дію на мікрофлору рідини, яка обробляється. Для утворення такого ефекту необхідні невелика інтенсивність ударної хвилі і порівняно велика частота розрядів, і час їх дії.
 Було проведено ряд досліджень по визначенню впливу електрохідравліч-ного ефекту на мікрофлору на експериментальній установці (рис.8) з між-електродними проміжками 16 та 20мм.
Було проведено ряд досліджень по визначенню впливу електрохідравліч-ного ефекту на мікрофлору на експериментальній установці (рис.8) з між-електродними проміжками 16 та 20мм.
Бактерицидна дія елек-трогідравлічного ефекту залежить від відстані між електродами і доцільніше використову-вати більшу відстань між ними.
Як показав мікробіо-логічний аналіз, саме електроіскрове оброблення дифузійного соку при напрузі 30 кВ та чотирьох імпульсах дало можливість інактивувати продуценти клітин у середньому на 88%. При чому чутливими до знезаражуючої дії електрогідравлічного ефекту виявилися вегетативні клітини бактерій, дріжджів, міцеліальних грибів. Резистентними до електроіскрового оброблення виявилися спори мікроміцетів і особливо бактерії Bac.Subtilіs та Bac.Cereus.
Виконаними дослідженнями встановлено, що електроіскрове оброблення дифузійного соку дозволяє досягти ефективного зменшення в ньому мікрофлори, що призведе до зменшення втрат цукрози за рахунок мікробіологічної діяльності і, таким чином, отримання більшої кількості кристалічного білого цукру.
Хімічні антисептики, які використовуються на сьогоднішній день, потребують зберігання приготування та дозування, а отже більших затрат робочої сили та часу на обслуговування. Деякі з використовуваних антисептиків досить токсичні і небажані для дезінфекції харчових напівпродуктів.
Використання ж електрогідравлічного ефекту не вимагає допоміжних затрат робочої сили і часу та при дотриманні правил безпеки є безпечним. За рахунок всього вищезазначеного запропонований метод дезінфекції дифузійного соку з використанням електрогідравлічного ефекту є менш трудомістким та більш ефективним за традиційні методи.

|
|
| а | б |
| |
| в |
Рис. 9. Влияние электрогидравлической обработки на общую микрофлору сокостружечной смеси в зависимости от количества разрядов при напряжении 35кВ.
а – контрольный образец; б – образец, обработанный 5-ю импульсами; в – образец, обработанный 10-ю импульсами.
3.6. Очищення соку. Розглядаючи тенденції в цукровій промисловості за останній час, слід сказати, що існуюча ПД була запроваджена в першу чергу для покращення седиментаційно-фільтраційних властивостей осаду соку І сатурації. Оскільки зараз все більшого застосування набувають автоматизовані фільтр-преси, питання про розміри частинок осаду та швидкість їх осадження вже не стоїть так гостро, тому що надлишковий тиск та таких фільтрах майже вдвічі більший. В такому разі на перше місце виходить задача покращення якості очищеного соку та створення на дефекосатурації осаду, що стискається з рівномірними складовими частинками, про що буде йти мова далі. Тому зараз на кафедрі ТЦ НУХТ ведуться роботи по створенню принципово нового способу попереднього вапнування дифузійного соку з використанням ефектів пароконденсаційної кавітації та маятникової дефекосатурації. Пілотний зразок пароконденсаційного апарату (ПКА) ПД успішно пройшов випробування на Ланівецькому цукровому заводі.
 Робота ПКА попередньої дефекації здійснювалась таким чином. Дифузійний сік поступав в ПКА попередньої дефекації, де одночасно оброблявся парою 3-го корпусу ВУ та вапняним молоком в кількості 0,05…0,2 % СаО до маси соку. Після оброблення сік поступав в апарат попередньої дефекації типу Брігель-Мюллера, в якому значення рН20 і лужність соку доводилися до оптимальних величин за рахунок повертання нефільтрованого соку І сатурації та вапняного молока.
Робота ПКА попередньої дефекації здійснювалась таким чином. Дифузійний сік поступав в ПКА попередньої дефекації, де одночасно оброблявся парою 3-го корпусу ВУ та вапняним молоком в кількості 0,05…0,2 % СаО до маси соку. Після оброблення сік поступав в апарат попередньої дефекації типу Брігель-Мюллера, в якому значення рН20 і лужність соку доводилися до оптимальних величин за рахунок повертання нефільтрованого соку І сатурації та вапняного молока.
оброблення дифузійного соку парою в ПКА попередньої дефекації призводить до повнішої коагуляції ВМС з утворенням малогідратоваого осаду коагуляту. При локальному перепаді температур внаслідок конденсації пари на поверхні краплини збільшується масообмін, який сприяє активній взаємодії нецукрів дифузійного соку з іоном кальцію. Вапняне молоко, попадаючи в зону розпилювання дифузійного соку та в парове середовище, активується, що також сприяє більш повному проходженню хімічних реакцій. За результатами досліджень оптимальний режим роботи ПКА попередньої дефекації дифузійного соку вважається при витратах пари 1,4 % та вапняного молока в кількості 0,1 % СаО до маси соку.
Враховуючи теперішні тенденції використання прес-фільтрів для одностадійної фільтрації соку І сатурації, проведення попередньої дефекації в апаратах пароконтактного типу дозволить різко скоротити тривалість даного процесу та зменшити, або й повністю відмовитися від рециркуляції не фільтрованого соку І сатурації на попередню дефекацію. До того ж апарат має невелику металоємкість, простий за конструкцією і може бути виготовлений безпосередньо в умовах цукрового заводу.
|
|
|
|
|
Дата добавления: 2014-01-07; Просмотров: 1087; Нарушение авторских прав?; Мы поможем в написании вашей работы!